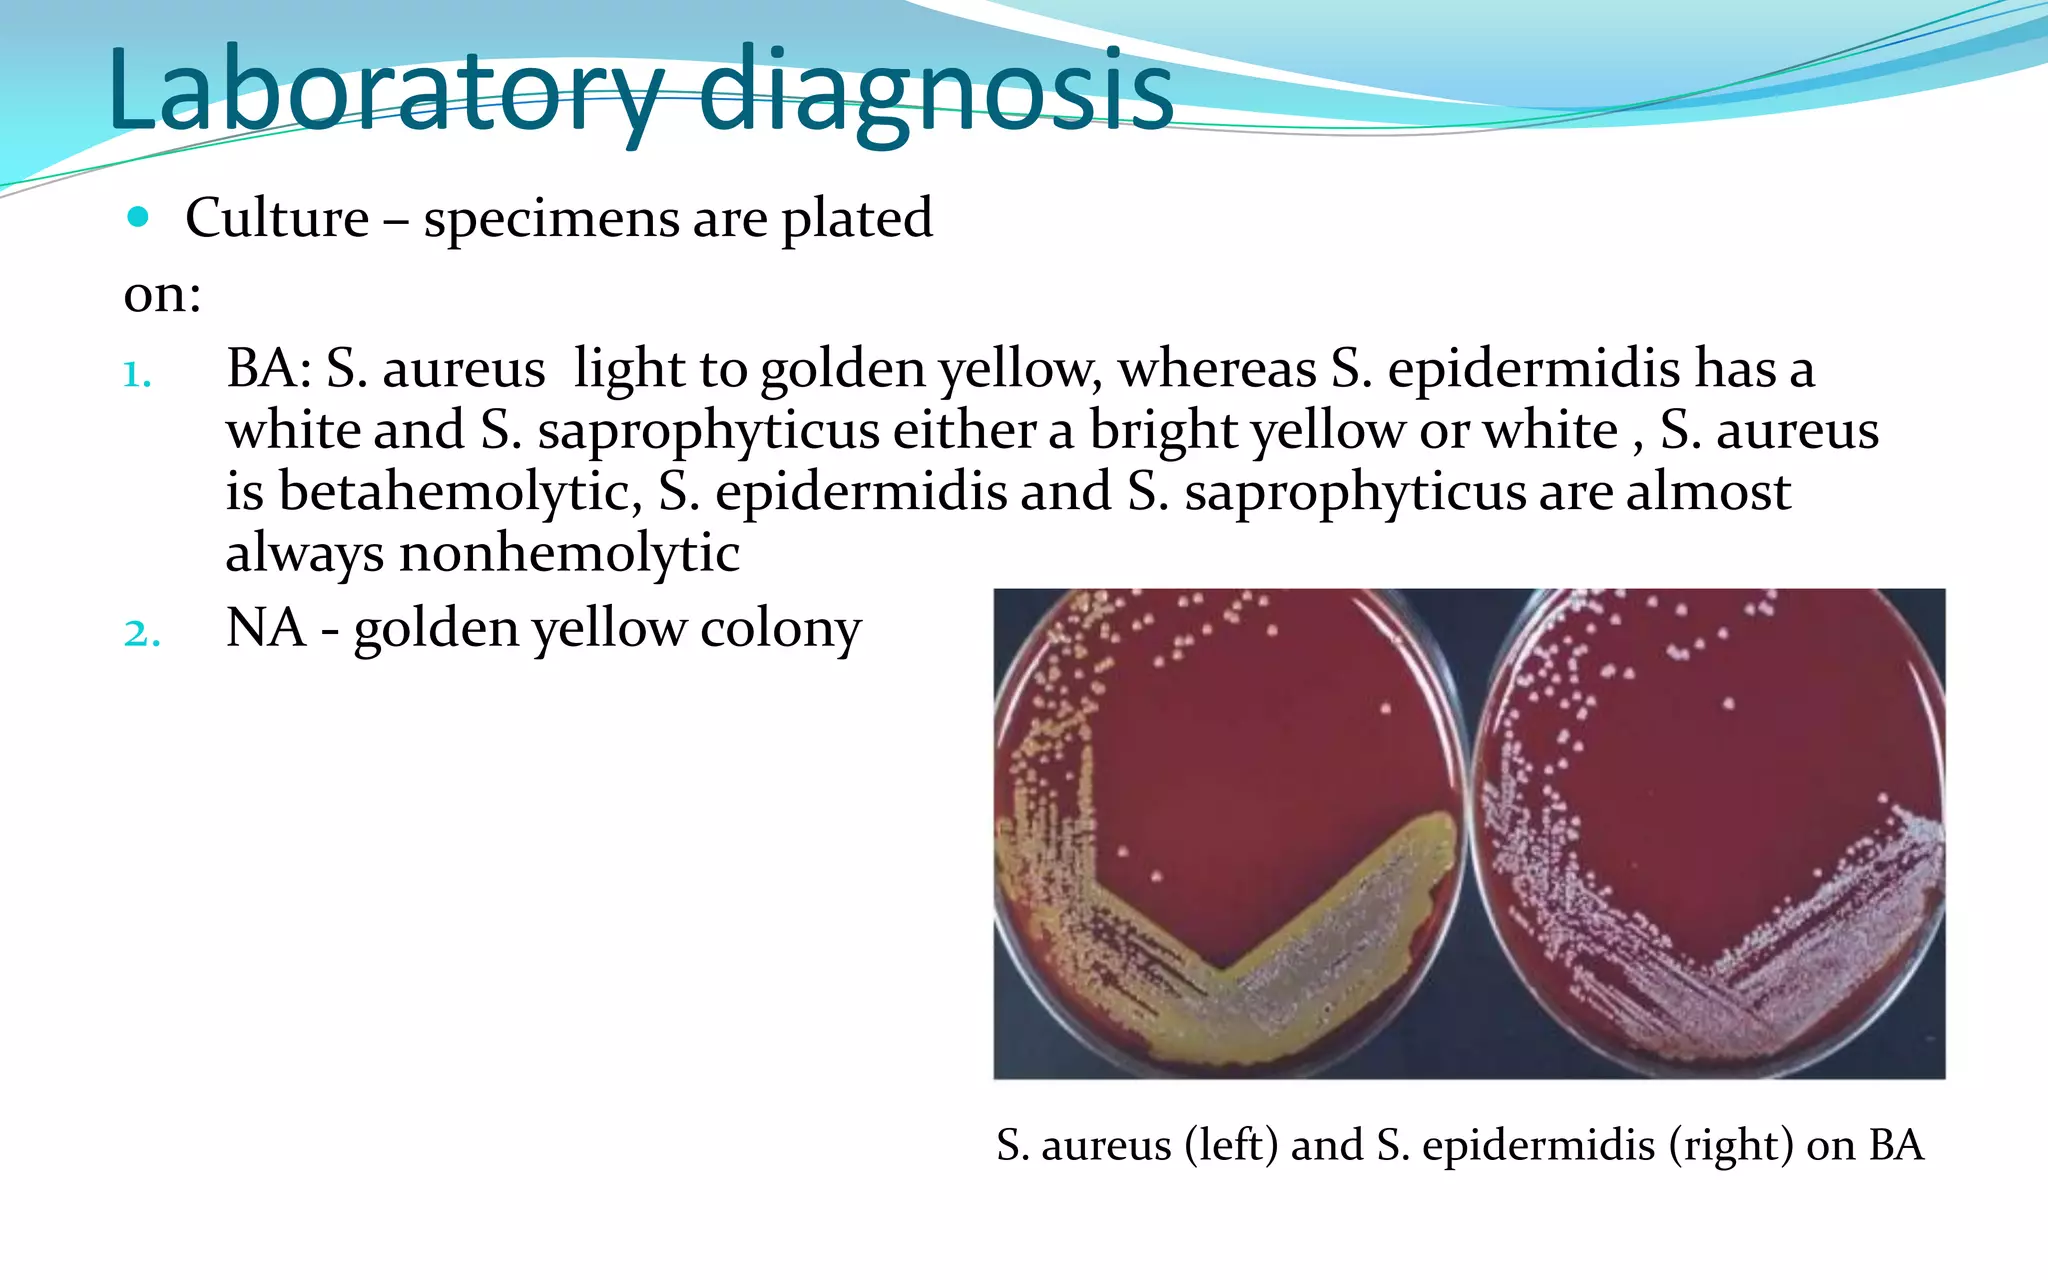
Laboratory diagnosis
 Culture – specimens are plated
on:
1. BA: S. aureus light to golden yellow, whereas S. epidermidis has a
white and S. saprophyticus either a bright yellow or white , S. aureus
is betahemolytic, S. epidermidis and S. saprophyticus are almost
always nonhemolytic
2. NA - golden yellow colony
S. aureus (left) and S. epidermidis (right) on BA
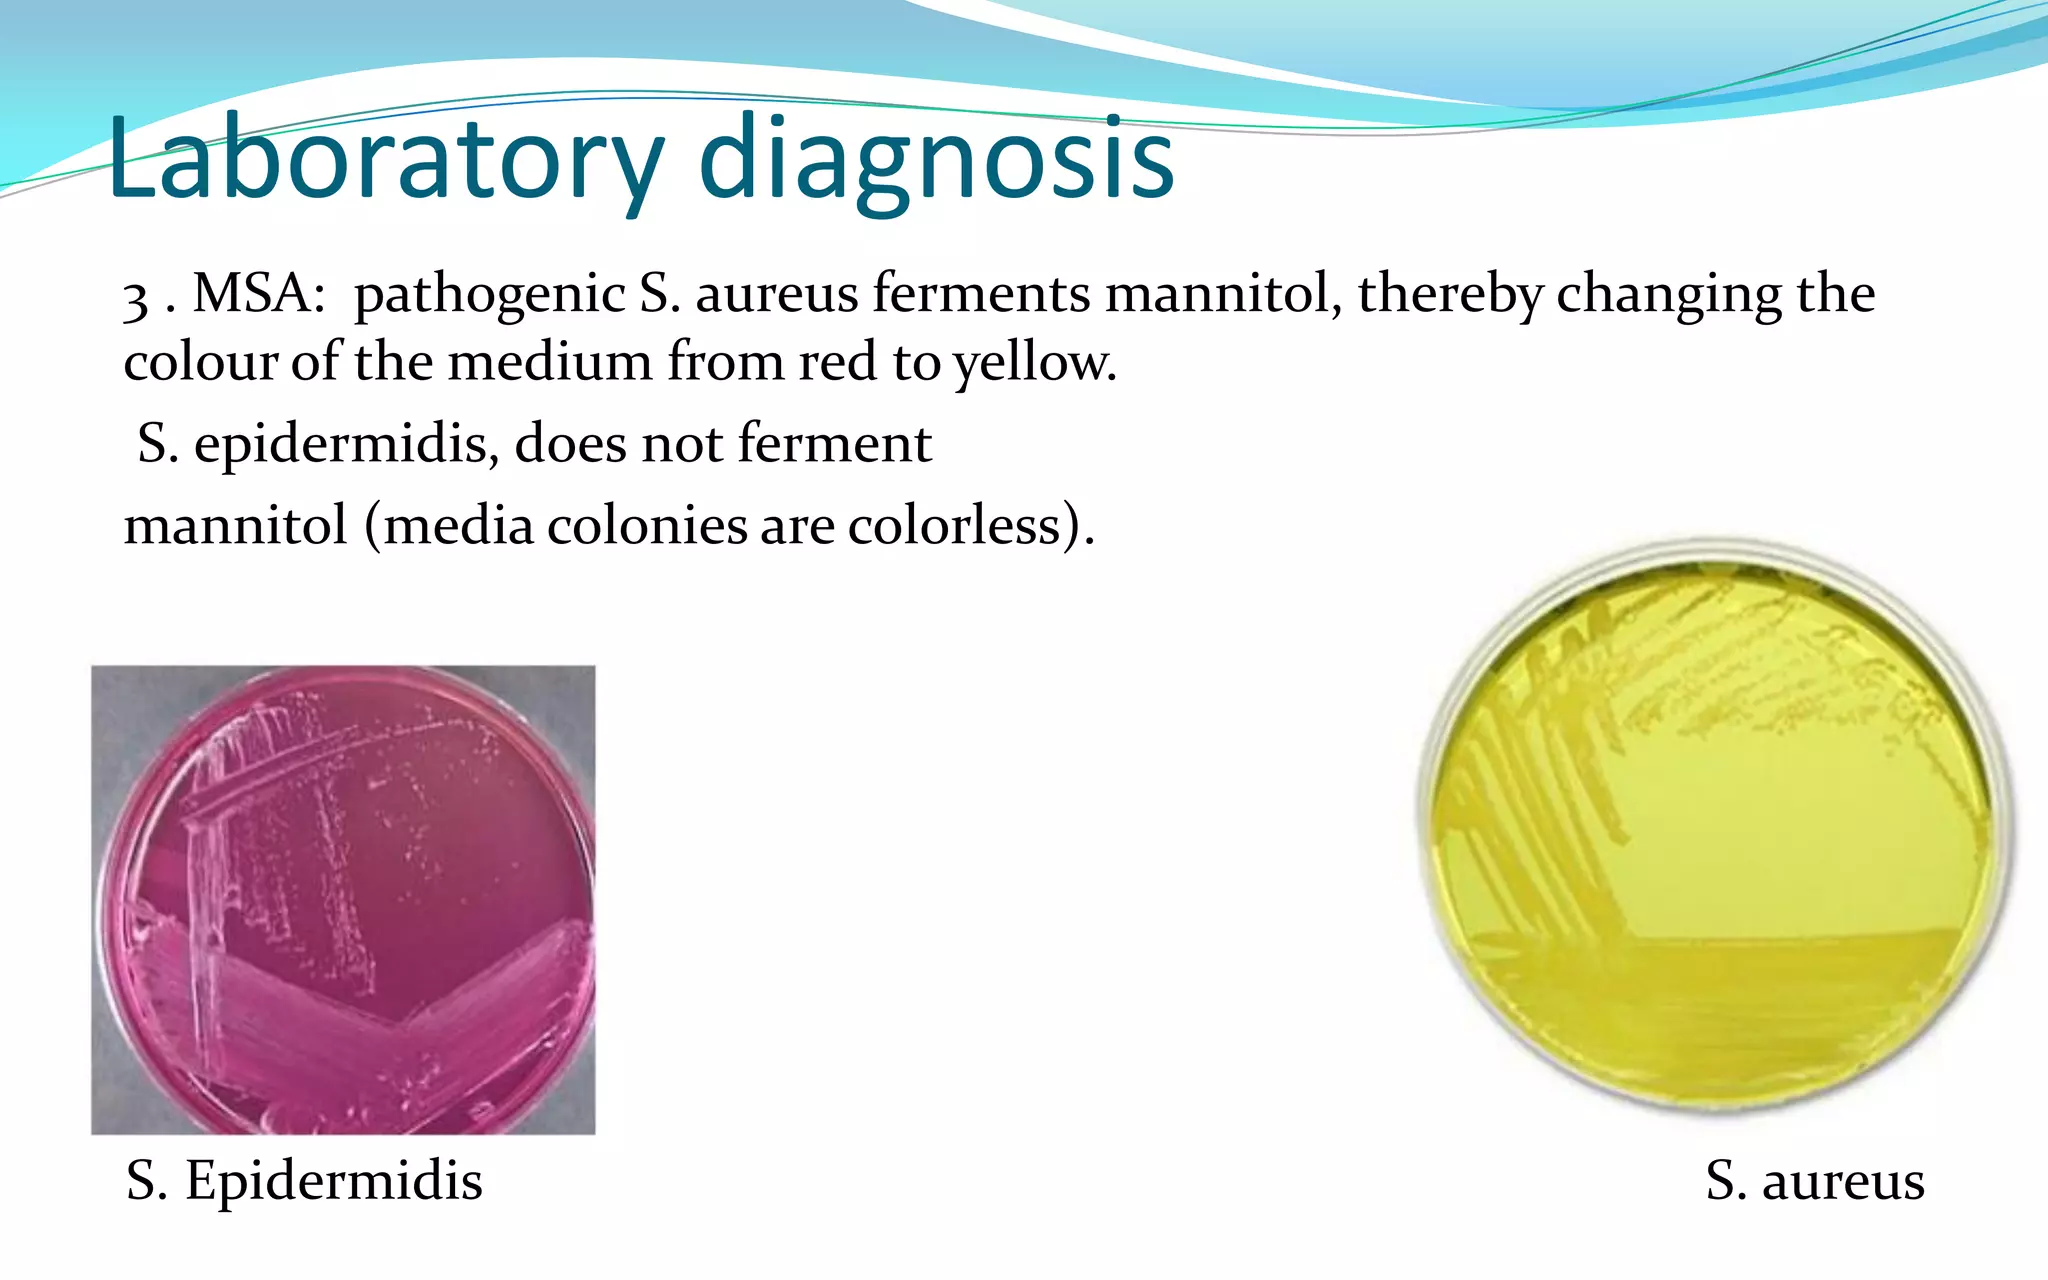
Laboratory diagnosis
3 . MSA: pathogenic S. aureus ferments mannitol, thereby changing the
colour of the medium from red to yellow.
S. epidermidis, does not ferment
mannitol (media colonies are colorless).
S. Epidermidis S. aureus

This document discusses Staphylococci bacteria, including their general features and important medical species. Staphylococci are gram-positive cocci that form grape-like clusters and are facultative anaerobes. Three medically important species are described: Staphylococcus aureus, S. epidermidis, and S. saprophyticus. S. aureus is the most virulent and causes a variety of infections through various cell-associated and secreted virulence factors. Laboratory diagnosis involves culturing specimens on selective media and performing tests like catalase, coagulase, and DNase.